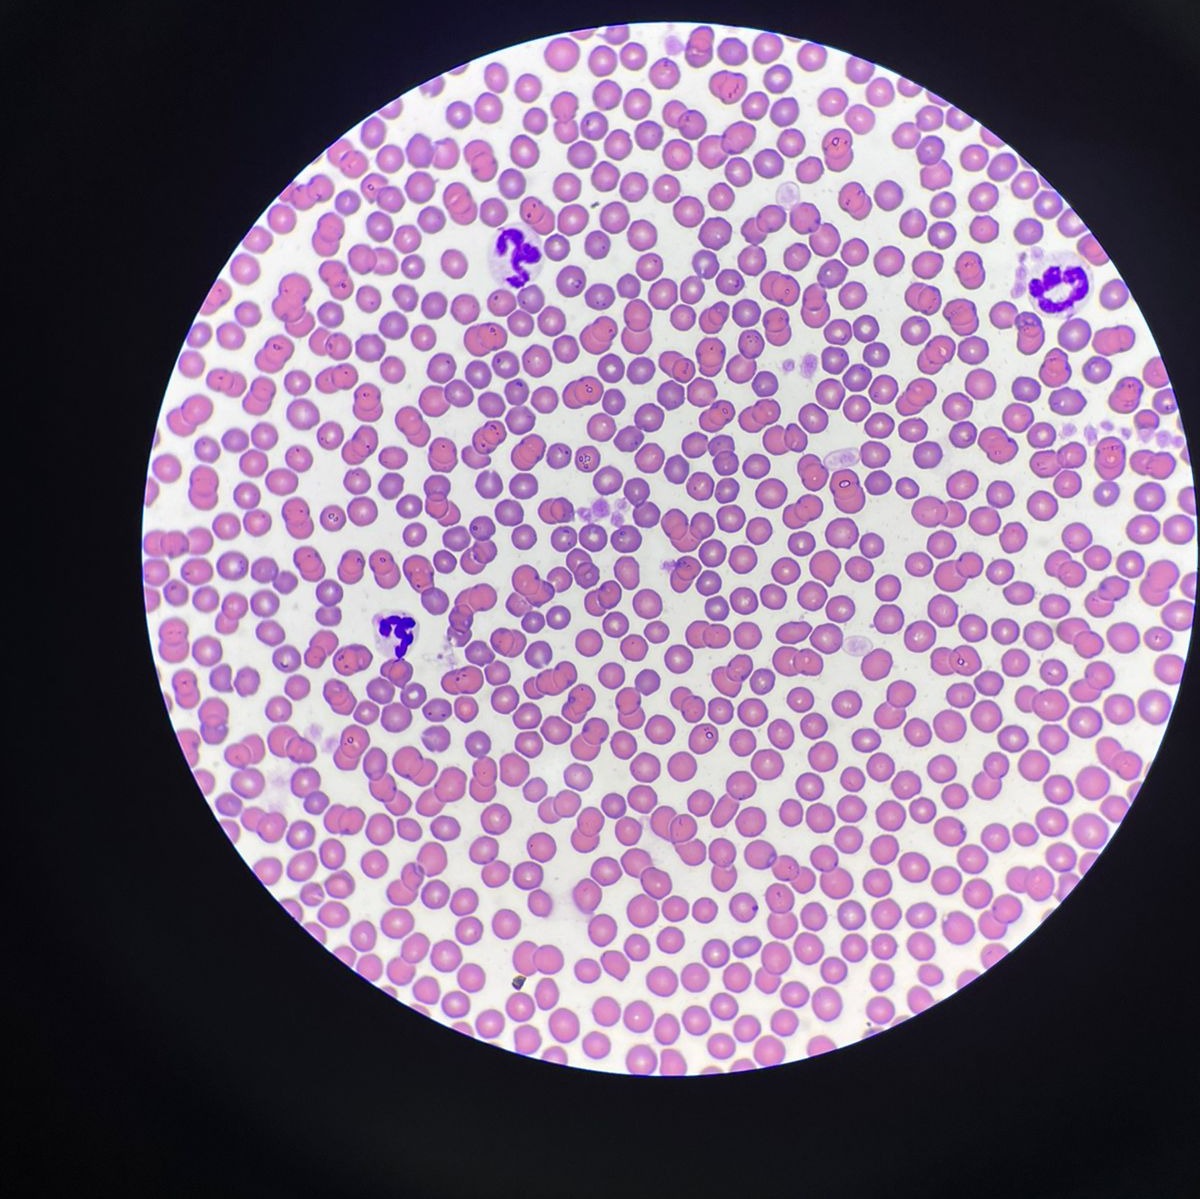

Masuk
hosting
Hidup ini memilih atau dipilih
0 EPISODE · 1 SUBSCRIBERS
Hidup ini memilih atau dipilih, hal ini tergantung keyakinan mu, selama kamu masih merasa jauh dari Tuhan , pilihlah yg membuat dekat dg Tuhan karena di suatu saat nanti kita akan kembali ke Tuhan
Subscribe



